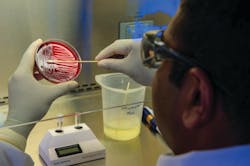
Lm P 28 Swabbing Photo By Cdc On Unsplash 60f5a6351cced Lm P 28 Swabbing Photo By Cdc On Unsplash 60f5a6351cced

When the basic consumables that clinical laboratorians need are in short supply, laboratory professionals and supply distributors must act quickly and creatively. The COVID-19 pandemic resulted in shortages of necessary medical laboratory supplies, so Medical Laboratory Observer contacted some suppliers for their perspectives on the pandemic and advice on future availability.
Pandemic stressed supply chain
She noted that most items went on backorder at some point during the pandemic; alternatives were needed, and guidance was appreciated. “Early on in the pandemic, there seemed to be confusion in hospitals and point-of-care facilities about the best transport media or collection device to use for COVID sampling; with the CDC’s (Centers for Disease Control and Prevention) help and guidance, that confusion was short lived.”
Amidst the COVID chaos, nobody really knew what to expect or what supply would next be added to the shortage list and put on backorder, requiring quick thinking for conflict resolution. Krhovsky said, “I think there were plenty of ‘surprises’ through the pandemic. I don’t think anyone foresaw the tremendous challenge on swabs and transport media.” The increased demands stressed supply chains unexpectedly during the pandemic. “Being surprised by certain events was inevitable.”
Worldwide lab supply shortages continue
Shortages from the pandemic continue to plague laboratories across the globe. In June 2021, the FDA released conservation strategies for sodium citrate blood specimen collection tubes, adding them as the latest item on the device shortage list.1 The FDA recommends not including sodium citrate tubes, which typically have a light blue top, in routine collections of a variety of specimens at the time of other blood sampling or IV insertion, saying not to use them unless it is medically necessary or for difficult blood collections. The FDA advises labs not to use the light-blue top tubes as discard tubes, instead suggesting clear top or red stopper tubes, with no additives, as an alternative. These include vacuum sample tubes, with anticoagulant, sodium citrate only, as well as additional tubes, vials, systems, serum separators, and blood collection with sodium citrate only. The shortage is expected through the end of the year.
In May, multi-target respiratory-specimen nucleic acid tests, including SARS-CoV-2 and other microbial agents, were added to the shortage list.1 Plastic for things like pipettes, general purpose reagents, transport culture medium, ventilators, masks, gowns and gloves, as well as microbial nucleic acid storage and stabilization devices continue to be in short supply, which may last for the duration of the pandemic.
While shortages sent people scrambling during the peak of the pandemic, some supplies are slowly starting to see less demand or have increased production. “There were several product categories that decreased amidst the pandemic. Plated media, routine POC testing, and histology related consumables just to name a few. Many of these products have subsequently bounced back in Q2 and are showing a continued uptick,” said Krhovsky.
Now that the frenzy of the peak of COVID is starting to subside, Krhovsky mentioned seeing lower levels of purchasing pandemic related items while conversely seeing an uptick in the pre-pandemic tests and supplies.Tips to surviving supply shortages
Templet’s advice for surviving supply shortages: “Communication is key, staying in close contact with sales reps and providing blanket orders and forecasts wherever possible helps.”
Krhovsky gave a tip that lab professionals should consider when purchasing consumables during times of shortages. “Partner with your supply chain partners who often have access to several different pathways to procure product. It also helps to have relationships and regular cadence with technical sales professionals from your prime distributors/manufacturers. That way, when an issue arises, you have an individual that has an intimate understanding of your operation and can respond accordingly. More than anything, though, stay open-minded. Clinical results are absolutely paramount, but in a time of crisis, it’s important to understand what options are both viable and available. That might require thinking outside of the box and breaking away from traditional brand preferences.”
Starting a system with dedicated, specific staff members who monitor products can help prevent running out of stock. Krhovsky mentioned partnering with supply chain counterparts on stock levels, ordering and procurement practices, as “often times, waste and/or scrap is commonly associated with ordering errors and inconsistencies, versus how the product is used or stored.”
Finding a positive within the pandemic, Krhovsky noted the increased interest in molecular testing and products. “The pandemic shined a very bright light on the benefits and shortcomings of different testing methodologies. Whether it was POC or instrument based, I believe molecular testing was one of the few silver linings of the past 18 months.”
He concluded with a nod to the behind-the-scenes heroes of the pandemic. “The labs in our country were nothing short of heroic during the height of the pandemic. There was an incredible amount of determination on the part of lab professionals and supply chain executives in terms of finding solutions on short notice. Validating and implementing new products on very short timelines represents challenges under normal circumstances. When you add staff shortages and increased workload, it becomes an even more valiant effort. I applaud these teams for getting it done under these unprecedented conditions.”
References
- Center for Devices and Radiological Health. Medical Device Shortages During the COVID-19 Public Health Emergency. U.S. Food and Drug Administration. https://www.fda.gov/medical-devices/coronavirus-covid-19-and-medical-devices/medical-device-shortages-during-covid-19-public-health-emergency#shortage. Accessed July 7, 2021.
About the Author
Marisa L. Williams
Editor
The author of more than 100 independently published books, Marisa L. Williams earned her Master’s at Johns Hopkins University, while interning on Capitol Hill, doing press and communications for the National Association of Community Health Centers. Creating her own Bachelor of Science degree at the University of Toledo, Williams blended pre-medical, pre-law, and laboratory studies, resulting in an interdisciplinary degree emphasizing Forensics. She has worked with Dr. Paulette Moulton (Levy), a dermatologist in Monroe, MI, as well as Dr. Elizabeth Triana, a family medicine practitioner specializing in hormone therapy, based out of Port Charlotte, FL; additionally, she has 20 years of experience as a multimedia journalist, is a third generation Realtor licensed in MI and FL, and has five years of college level teaching experience.